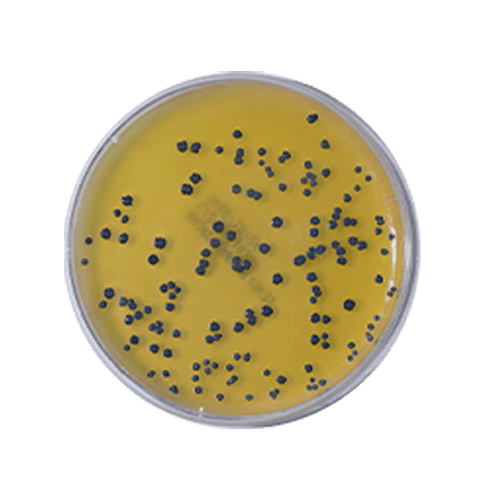

O ágar Baird-Parker é um meio de cultura seletivo e diferencial projetado para a identificação de Staphylococcus aureus, especialmente, em amostras de alimentos e ambientes de processamento. O ágar inibe o crescimento de bactérias não desejadas e destaca S. aureus por meio da formação de colônias negras, resultante da redução de ácido telurito. Este meio é amplamente utilizado na análise de alimentos para a detecção e quantificação de S. aureus, ajudando a garantir a segurança e a qualidade dos produtos.